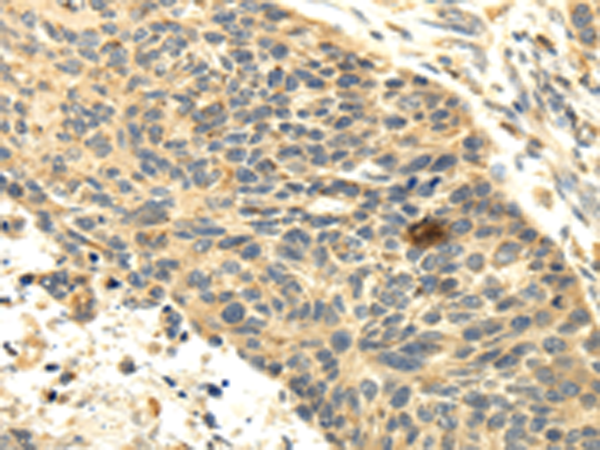
一抗

中文名稱:兔抗SEMA4F多克隆抗體
英文名稱: Anti-SEMA4F rabbit polyclonal antibody
別 名: S4F; SEMAM; SEMAW; M-SEMA; PRO2353; m-Sema-M
相關(guān)類別: 一抗
儲 存: 冷凍(-20℃)
宿 主:Rabbit
抗 原: SEMA4F
反應(yīng)種屬: Human, Mouse, Rat
標(biāo)記物: Unconjugate
克隆類型: rabbit polyclonal
技術(shù)規(guī)格
|
Background: |
This gene encodes a transmembrane class IV semaphorin family protein, which plays a role in neural development. This gene may be involved in neurogenesis in prostate cancer, the development of neurofibromas, and breast cancer tumorigenesis. Alternative splicing results in multiple transcript variants. |
|
Applications: |
ELISA, IHC |
|
Name of antibody: |
SEMA4F |
|
Immunogen: |
Fusion protein of human SEMA4F |
|
Full name: |
sema domain, immunoglobulin domain (Ig), transmembrane domain (TM) and short cytoplasmic domain, (semaphorin) 4F |
|
Synonyms: |
S4F; SEMAM; SEMAW; M-SEMA; PRO2353; m-Sema-M |
|
SwissProt: |
O95754 |
|
ELISA Recommended dilution: |
2000-5000 |
|
IHC positive control: |
Human esophagus cancer and human brain |
|
IHC Recommend dilution: |
25-100 |

 購物車
購物車 幫助
幫助
 021-54845833/15800441009
021-54845833/15800441009